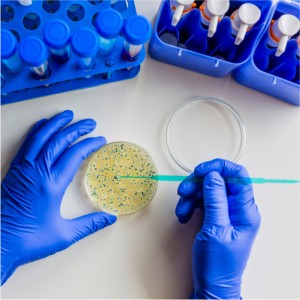

Menú
- Ofertas
-
Productos
- Aparataje
- Algodón
- Apósito
- Aspiración
- Campos cirugía
- Compresa-gasa
- Consumibles
- Desinfección
-
Diagnóstico
- Audiometría
- Cronómetros
- Dermatoscopios
- Diapasón
- Ecógrafos
- Electrocardiógrafos
- Espirómetros
- Fonendoscopios
- Glucómetros
- Goniómetros
- Lentes
- Linternas
- Maletín
- Medición
- Microscopios
- Monitor constantes
- Oftalmoscopios
- Otoscopios
- Pulsioxímetro
- Rinoscopios
- Tensiómetros
- Termómetros
- Visión
- Otros para diagnóstico
- Empapador
- Equipos prevención técnica
- Esparadrapo
- Esterilización
- Fisioterapia-rehabilitación
- Guantes
- Higiene-limpieza
- Imprenta
- Informática
- Instrumental
-
Inyección-infusión
- Adaptadores
- Aguja dental
- Aguja espinal
- Aguja hipodérmica microlance bd
- Aguja hipodérmica mesoterapia
- Aguja hipodérmica Braun
- Aguja hipodérmica sol-m
- Aguja seguridad bd
- Aguja vacutainer
- Aguja de punción
- Aguja hipodérmica nipro
- Aguja seguridad nipro
- Catéteres
- Equipos de infusión
- Palomillas vacutainer
- Palomillas venofix epicraneal
- Pistola intraósea
- Jeringas
-
Laboratorio material
- Accesorio extracción sangre
- Agitador
- Agua
- Apoya brazo
- Asa-escobillón
- Aspiración
- Capilares
- Centrífuga
- Contenedores residuos biológicos
- Cubilete
- Dosificadores
- Espátula
- Estufa
- Gradillas
- Microtubo
- Microscopía y tinción
- Papel filtro
- Peras
- Ph
- Pipeta
- Placa
- Portatubo
- Prueba glucosa
- Puntas pipeta
- Químicos
- Recogida muestra
- Tapón
- Tubo sin vacío
- Tubo con vacío
- Tubo: otros
- Transporte de muestras
- Vaso y matraz
- Otros materiales laboratorio
- Roche preanalítica
-
Laboratorio reactivos
- Alonso alegre pruebas rápidas
- Becton dickinson discantibiótic
- Becton dickinson pruebas rápidas
- Biomerieux reactivos
- Monlab hematología
- Monlab pruebas rápidas
- Roche bioquímica
- Roche coagulación
- Sysmex hematología
- Roche inmunología
- Roche molecular
- Roche pruebas rápidas
- Roche serología
- Roche papel impresión
- Sysmex velocidad
- Otros reactivos
- Roche hematología
- Roche urianálisis
-
Material oficina
- Archivo
- Bandejas
- Banderitas/marcadores
- Bolígrafos
- Borrador
- Bridas
- Cajas
- Calculadoras
- Calendarios
- Carpetas-subcarpetas
- Cartulinas
- Cinta adhesiva
- Cinta embalaje
- Clasificador
- Clips
- Corrector
- Cuadernos
- Cubiletes
- Cutter
- Dossier
- Dymo
- Encuadernación
- Espirales
- Etiquetas/etiquetadoras
- Film
- Folios-hojas
- Fundas
- Goma borrar
- Goma elástica
- Gomets
- Grapadoras
- Grapas
- Índice
- Lápiz
- Libro subcontratación
- Listín telefónico
- Marcadores
- Metro
- Minas y portaminas
- Nota adhesiva
- Papelería
- Papelera
- Pegamento
- Pilas
- Pinza
- Pizarras
- Plástico burbuja
- Portatarjetas
- Portarollos
- Proyección
- Reglas
- Rotuladores
- Sacapuntas
- Sello
- Señalización
- Separadores
- Sobres/bolsas
- Tableros corcho
- Taladros
- Tapas-cubiertas
- Tijera
- Tinta
- Otro material oficina
- Mobiliario clínico
- Mobiliario general
- Ortopedia
- Parafarmacia
- Podología
- Primeros auxilios-reanimación
- Protección
- Sondaje
- Sueros
- Sutura
- Vendas-férulas
- Vestuario-epis
- Especialidades
- Tendencias
-
Productos
- Aparataje
- Algodón
- Apósito
- Aspiración
- Campos cirugía
- Compresa-gasa
- Consumibles
- Desinfección
-
Diagnóstico
- Audiometría
- Cronómetros
- Dermatoscopios
- Diapasón
- Ecógrafos
- Electrocardiógrafos
- Espirómetros
- Fonendoscopios
- Glucómetros
- Goniómetros
- Lentes
- Linternas
- Maletín
- Medición
- Microscopios
- Monitor constantes
- Oftalmoscopios
- Otoscopios
- Pulsioxímetro
- Rinoscopios
- Tensiómetros
- Termómetros
- Visión
- Otros para diagnóstico
- Empapador
- Equipos prevención técnica
- Esparadrapo
- Esterilización
- Fisioterapia-rehabilitación
- Guantes
- Higiene-limpieza
- Informática
- Instrumental
-
Inyección-infusión
- Adaptadores
- Aguja dental
- Aguja espinal
- Aguja hipodérmica microlance bd
- Aguja hipodérmica mesoterapia
- Aguja hipodérmica Braun
- Aguja hipodérmica sol-m
- Aguja seguridad bd
- Aguja vacutainer
- Aguja de punción
- Aguja hipodérmica nipro
- Aguja seguridad nipro
- Catéteres
- Equipos de infusión
- Palomillas vacutainer
- Palomillas venofix epicraneal
- Pistola intraósea
- Jeringas
-
Laboratorio material
- Accesorio extracción sangre
- Agitador
- Agua
- Apoya brazo
- Asa-escobillón
- Aspiración
- Capilares
- Centrífuga
- Contenedores residuos biológicos
- Cubilete
- Dosificadores
- Espátula
- Estufa
- Gradillas
- Microtubo
- Microscopía y tinción
- Papel filtro
- Peras
- Ph
- Pipeta
- Placa
- Portatubo
- Prueba glucosa
- Puntas pipeta
- Químicos
- Recogida muestra
- Tapón
- Tubo sin vacío
- Tubo con vacío
- Tubo: otros
- Transporte de muestras
- Vaso y matraz
- Otros materiales laboratorio
- Roche preanalítica
-
Material oficina
- Archivo
- Bandejas
- Banderitas/marcadores
- Bolígrafos
- Borrador
- Bridas
- Cajas
- Calculadoras
- Calendarios
- Carpetas-subcarpetas
- Cartulinas
- Cinta adhesiva
- Cinta embalaje
- Clasificador
- Clips
- Corrector
- Cuadernos
- Cubiletes
- Cutter
- Dossier
- Dymo
- Encuadernación
- Espirales
- Etiquetas/etiquetadoras
- Film
- Folios-hojas
- Fundas
- Goma borrar
- Goma elástica
- Gomets
- Grapadoras
- Grapas
- Índice
- Lápiz
- Libro subcontratación
- Listín telefónico
- Marcadores
- Metro
- Minas y portaminas
- Nota adhesiva
- Papelería
- Papelera
- Pegamento
- Pilas
- Pinza
- Pizarras
- Plástico burbuja
- Portatarjetas
- Portarollos
- Proyección
- Reglas
- Rotuladores
- Sacapuntas
- Sello
- Señalización
- Separadores
- Sobres/bolsas
- Tableros corcho
- Taladros
- Tapas-cubiertas
- Tijera
- Tinta
- Otro material oficina
- Mobiliario clínico
- Mobiliario general
- Ortopedia
- Parafarmacia
- Podología
- Primeros auxilios-reanimación
- Protección
- Sondaje
- Sueros
- Sutura
- Vendas-férulas
- Vestuario-epis
- Especialidades
- Todas las marcas
- Calidad
Comprar por Categoría
Laboratorio material
-
- Accesorio extracción sangre
- Agitador
- Agua
- Apoya brazo
- Asa-escobillón
- Aspiración
- Capilares
- Centrífuga
- Contenedores residuos biológicos
- Cubilete
- Dosificadores
- Espátula
- Estufa
- Gradillas
- Microtubo
- Microscopía y tinción
- Papel filtro
- Peras
- Ph
- Pipeta
- Placa
- Portatubo
- Prueba glucosa
- Puntas pipeta
- Químicos
- Recogida muestra
- Tapón
- Tubo sin vacío
- Tubo con vacío
- Tubo: otros
- Transporte de muestras
- Vaso y matraz
- Otros materiales laboratorio
- Roche preanalítica
Filtrar por
Precio
Precio
-
0,00 € - 1.613,00 €
Categorías
Categorías
Marca
Marca
Laboratorio material
Subcategorías
Filtros activos
Filtrar por
Precio
Precio
-
0,00 € - 1.613,00 €
Categorías
Categorías
Marca
Marca
8,71 € (Impuestos incl.)
AGUA DESTILADA B.BRAUN 100 ML ECOLAV PARA IRRIGACIÓN Y LAVADO...
Ref. Fabricante: 387872
Ref. Propia: 1315A145
Ref. Propia: 1315A145
34,00 € (Impuestos incl.)
25,53 € (Impuestos incl.)
AGUA DESTILADA B.BRAUN 500 ML ECOTAINER TAPÓN ROSCA (CAJA 10 UDS)
Ref. Fabricante: 143882
Ref. Propia: 1315A186
Ref. Propia: 1315A186
26,62 € (Impuestos incl.)
30,43 € (Impuestos incl.)
FILTRO DE INFUSIÓN INTRAPUR 0,2 μm PARA LA RETENCIÓN DE...
Ref. Fabricante: 4099713
Ref. Propia: 1316A144
Ref. Propia: 1316A144
656,13 € (Impuestos incl.)
LANCETAS ESTÉRILES ROMED EN ENVASE UNITARIO (PAQ. 200 UDS)
Ref. Fabricante: BL-200 (119-115)
Ref. Propia: 1326A101
Ref. Propia: 1326A101
8,35 € (Impuestos incl.)
0,63 € (Impuestos incl.)
52,26 € (Impuestos incl.)
TORNIQUETETORTOR LIBRE DE LÁTEX COLOR AZUL BD (PAQ. 25 UDS)
Ref. Fabricante: 367198
Ref. Propia: 1326A107
Ref. Propia: 1326A107
10,16 € (Impuestos incl.)
MENALANCET PRO LANCETAS USO PROFESIONAL BIOSEGURIDAD 23G (PAQ....
Ref. Fabricante: 42122
Ref. Propia: 1326A110
Ref. Propia: 1326A110
34,07 € (Impuestos incl.)
TORNIQUETETORTOR LIBRE DE LÁTEX CON CIERRE SEGURIDAD RIESTER...
Ref. Fabricante: 865-400
Ref. Propia: 1326A133
Ref. Propia: 1326A133
21,45 € (Impuestos incl.)
27,39 € (Impuestos incl.)
















